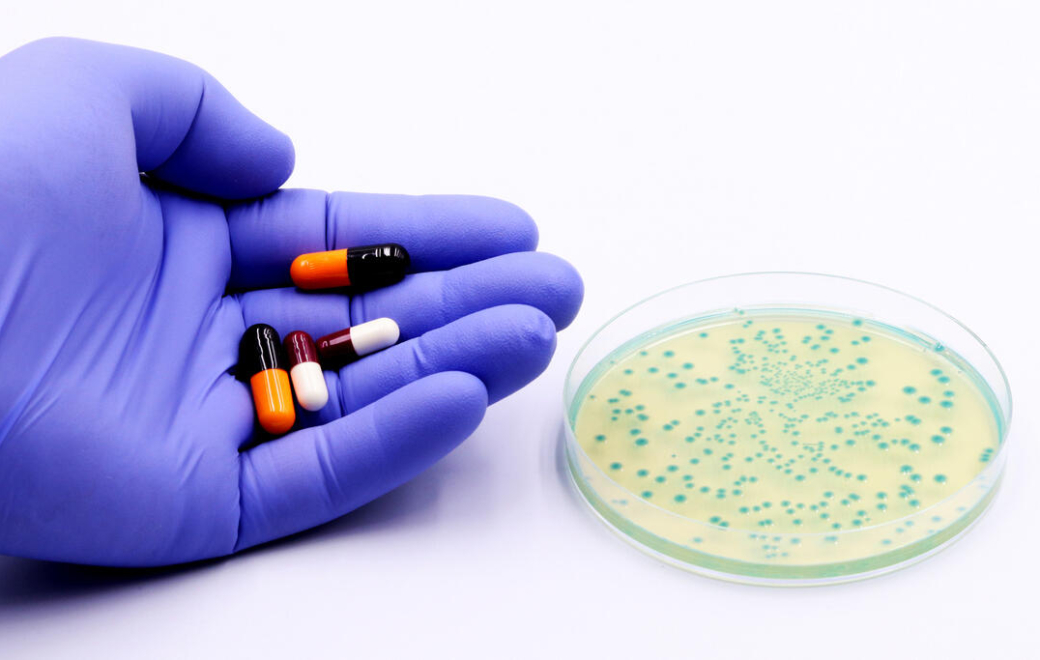
Antibiorésistance : les recommandations de sept académies de santé

- Accueil ›
- Conseils ›
- Pathologies ›
- Antibiorésistance : les recommandations de sept académies de santé
© Getty Images
Antibiorésistance : les recommandations de sept académies de santé
Un colloque interacadémique sur le thème de l’antibiorésistance a eu lieu au mois de juin 2024. Voici les principales recommandations qui en découlent.
Les académies de médecine, de pharmacie, de chirurgie, de chirurgie dentaire, d’agriculture, des sciences et vétérinaire mettent depuis 12 ans leurs connaissances en commun pour lutter contre l’antibiorésistance. Le dernier colloque a rappelé l’importance de l’approche « Une seule santé ou One Health » pour permettre la détection des tendances émergentes et adapter l’orientation des politiques de santé publique.
Des découvertes récentes ont montré que des xénobiotiques (médicaments non antibiotiques, polluants, additifs alimentaires) pouvaient engendrer de la résistance croisée avec les antibiotiques. Ou que, à l’inverse de la résistance liée à l’acquisition horizontale d’un gène à partir d’une autre bactérie (transrésistance ou cross-résistance), le développement d’une résistance à certains antibiotiques peut rendre une bactérie plus sensible à un autre antibactérien (sensibilité collatérale). De nombreux travaux de recherche tentent également de décrypter les mécanismes moléculaires impliqués dans les pompes d’efflux, transporteurs membranaires qui peuvent expulser les antibiotiques des bactéries. Les académies recommandent donc de « prescrire, délivrer et utiliser les antibiotiques avec parcimonie », de « considérer la résistance croisée entre les diverses classes d’antibiotiques et les antiseptiques », et de « prendre en compte les mécanismes de résistance existants avant l’exposition des bactéries à de nouvelles molécules ».
Un focus a été fait sur les infections à Clostridioides difficile, pour lesquelles il importe de « mieux connaître les relations hôtes-pathogènes (métaboliques, inflammatoires) » associées à leur développement.
- Comptoir officinal : optimiser l’espace sans sacrifier la relation patient
- Reishi, shiitaké, maitaké : la poussée des champignons médicinaux
- Budget de la sécu 2026 : quelles mesures concernent les pharmaciens ?
- Cancers féminins : des voies de traitements prometteuses
- Vitamine A Blache 15 000 UI/g : un remplaçant pour Vitamine A Dulcis





